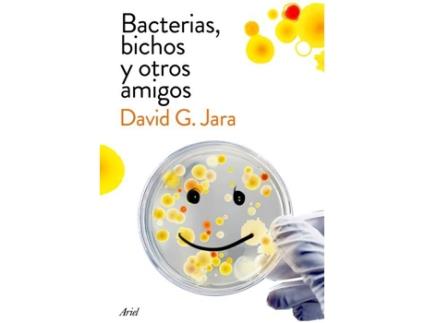
Livro Bacterias, Bichos Y Otros Amigos

1/1
1/1

Compare preços para ZEBLAZE Livro Bacterias, Bichos Y Otros Amigos, compre sempre com o preço mais baixo e em segurança








O nosso principal objetivo é ajudar-te a encontrar o teu produto, pelo menor preço, de forma simples e segura.
Copyright 2025 Forretas. Todos os direitos reservados.
